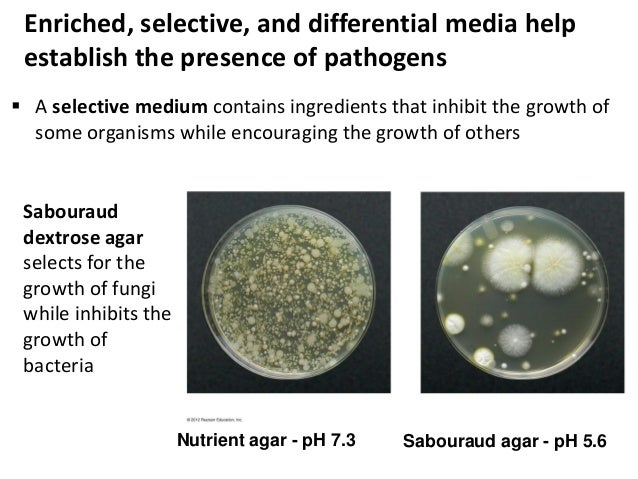
3 bio265 microbial growth instructor dr di bonaventura

If you are looking for PPT - Lecture #2 PowerPoint Presentation - ID:2002570 you've visit to the right place. We have 9 Images about PPT - Lecture #2 PowerPoint Presentation - ID:2002570 like PPT - Lecture #2 PowerPoint Presentation - ID:2002570, Xanthomonas Citri, 978-613-1-47494-1, 613147494X ,9786131474941 and also PPT - Lecture #2 PowerPoint Presentation - ID:2002570. Here it is:
PPT - Lecture #2 PowerPoint Presentation - ID:2002570
 www.slideserve.com
www.slideserve.com domain lecture ppt powerpoint presentation bacteria archaea eukarya
PPT - Chapter 27 & 28 PowerPoint Presentation, Free Download - ID:1711088
 www.slideserve.com
www.slideserve.com chapter ppt powerpoint presentation
Dandogram Of 11 Green Pea Isolates And Commercial Strain Derived From
 www.researchgate.net
www.researchgate.net isolates strain
ESSENTIALS OF BIODIVERSITY DATA BASE DR M P
 present5.com
present5.com biodiversity
Xanthomonas Citri, 978-613-1-47494-1, 613147494X ,9786131474941
 www.morebooks.de
www.morebooks.de xanthomonas citri
Alpha Diversity Indexes (Richness, Shannon And Phylogenetic Diversity
 www.researchgate.net
www.researchgate.net richness phylogenetic indexes fungi
Lb Agar Recipe Lab Rat | Bryont Rugs And Livings
 bryont.net
bryont.net Acetylcholine-producing T Cells In The Intestine Regulate Antimicrobial
 journals.physiology.org
journals.physiology.org intestine th17 acetylcholine cells producing
3 Bio265 Microbial Growth Instructor Dr Di Bonaventura
www.slideshare.net
www.slideshare.net microbial bio265 bonaventura instructor selective
3 bio265 microbial growth instructor dr di bonaventura. Xanthomonas citri. Lb agar recipe lab rat